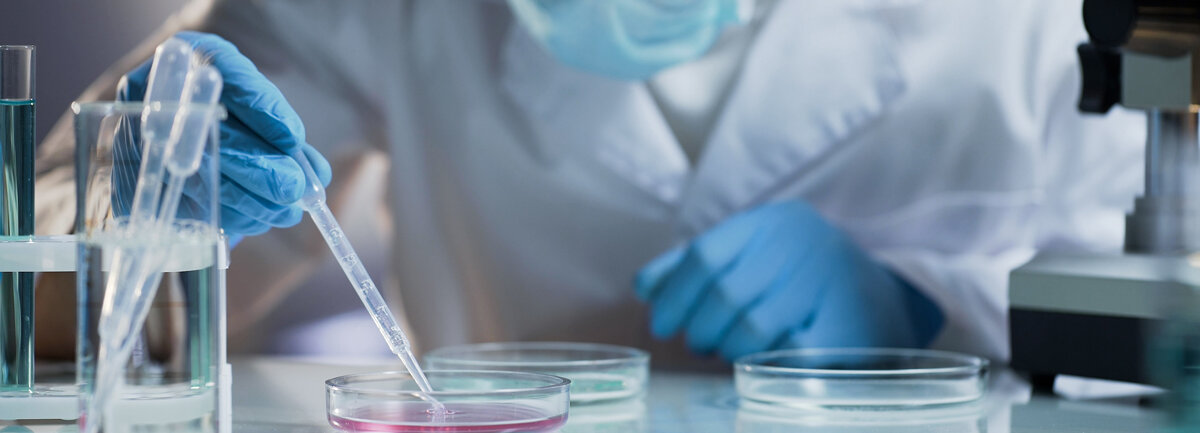

Studie | Neue Bakterienarten
IMMER NOCH EIN UNBEKANNTES WESEN: UNSER DARM-MIKROBIOM
Seite 1/1 2 Minuten
13 133 – das ist die Anzahl der Menschen, deren Gedärm unter die Lupe genommen wurde. Die Probanden kamen aus aller Welt. Man wollte die Zusammensetzung des immer noch zu weiten Teilen unerforschten Mikrobioms erkunden, denn diese „Flora“ ist für unsere Gesundheit von entscheidender Bedeutung: Die Bakterien lenken unser Immunsystem, kontrollieren wie Medikamente wirken oder steuern das Sättigungsgefühl – sie bestimmen also in entscheidender Weise über unsere Gesundheit. Und obwohl die Forscher bereits eine Vielzahl typischer Darmbakterien identifiziert haben, ist die genaue Zusammensetzung dessen, was früher „Darmflora“ genannt wurde, ihnen immer noch ein Buch mit sieben Siegeln. Wahrscheinlich, vermuteten die Wissenschaftler, gibt es eine Vielzahl von Spezies, die noch im Verborgenen in unserem Verdauungstrakt leben. „Diese unbekannten Mitglieder der Bakteriengemeinschaft können uns aus vielfältigen Gründen bisher entgangen sein – zum Beispiel, weil sie sehr selten sind oder sich nur schlecht außerhalb des Darms kultivieren lassen“, schreiben Alexandre Almeida vom Wellcome Sanger Institute in Hinxton und seine Kollegen.
Die Forscher nutzten in ihrer großen Untersuchung die sogenannte Shotgun-Metagenomik-Methode, bei der die gesamte DNA einer mikrobiellen Probe untersucht wird. Anhand dieser Informationen können Rückschlüsse auf die Bakterienarten gezogen werden. 1952 Spezies wurden entdeckt, die bisher völlig unbekannt waren: „Mit den von uns identifizierten Bakteriengenomen erweitert sich das bekannte Arten-Repertoire um 281 Prozent“, schreibt das Team. Wie sie berichteten, gehören die meisten rekonstruierten Genome dabei zur Klasse Clostridia.
Die neuen Bakterienspezies kamen dabei häufiger in den Mikrobiomen aus Afrika und Südamerika vor – insbesondere bei Bevölkerungsgruppen, die keinen westlichen Lebensstil pflegten. Die Beobachtung könnte nach Ansicht der Forscher auch erklären, warum die neuen Sorten bisher unter dem Radar blieben. Denn für die Erforschung des menschlichen Mikrobioms wurden bisher vor allem Menschen aus Europa und Nordamerika untersucht. Dies zeigt ihnen zufolge, dass in dieser Hinsicht noch eine signifikante Wissenslücke besteht: Es fehlt noch an Daten aus anderen Regionen der Welt.
Forschungsarbeiten wie diesen trügen dazu bei, eine Art Blaupause des menschlichen Darms zu kreieren und seine Rolle für Gesundheit und Krankheit genauer zu verstehen, so die Autoren der Studie. Die knapp 2000 neuen Arten geben der Wissenschaft künftig jede Menge Möglichkeiten, den Einfluss der Darmflora auf unseren Körper zu verstehen.
Alexandra Regner,
PTA und Journalistin
Quelle: www.wissenschaft.de